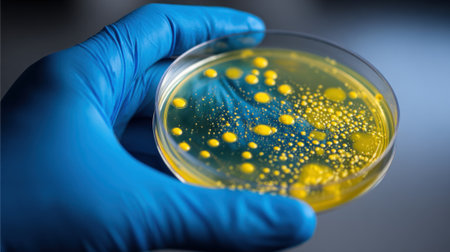
A laboratory technician in blue gloves carefully holds a petri dish containing vibrant yellow bacterial colonies.の素材

素材 - A laboratory technician in blue gloves carefully holds a petri dish containing vibrant yellow bacterial colonies.
作品情報
A laboratory technician in blue gloves carefully holds a petri dish containing vibrant yellow bacterial colonies.
- ID:261706382
- 作品種別:
- 作者名:formoney
キーワード
- agar plate
- analysis
- bacterial growth
- bioengineering
- biohazard
- biology
- biotechnology
- blue gloves
- cell culture
- cell growth
- contamination
- culture medium
- education
- experiment
- experimentation
- growth media
- health science
- lab environment
- laboratory
- laboratory equipment
- laboratory study
- medical
- microbiologist
- microbiology
- observation
- observation skills
- petri dish
- petri plate
- pharmaceutical
- research lab
- research methods
- research studies
- safety
- scientific research
- scientific study
- sterile environment
- sterile technique
- technician
- techniques
- wet lab
- yellow colonies
類似作品
Peace sign with...
Horizontal shot...
A close-up view...
Researchers wor...
scientist or do...
biochemical res...
View of female ...
Close Up Of Fem...
Dentist wearing...
Gloved Hand Hol...
Crop close up o...
A close-up of a...
Researchers wor...
Surgeon s glove...
A male doctor...
Doctor in medic...
Blue latex glov...
Close-up of a d...
chemist,scienti...
Female doctor b...
Professional do...
Hand scientist ...
Researcher usin...
Chemists in a l...
Researchers wor...
Close up of fem...
chemist,scienti...
Doctor medical ...
Nurse in steril...
two scientists ...
Coronavirus pan...
Medicine and Su...
Research, exper...
Woman in blue m...
Researchers wor...
A dentists hand...
Woman researche...
Laboratory phar...
lab, team of me...
Bioarcheology. ...
chemist,scienti...
Lab assistant, ...
Doctor's hand i...
The guy in glov...
Woman in hazmat...
doctor presses ...
A metal coin in...
Woman doctor is...
A blue medical ...